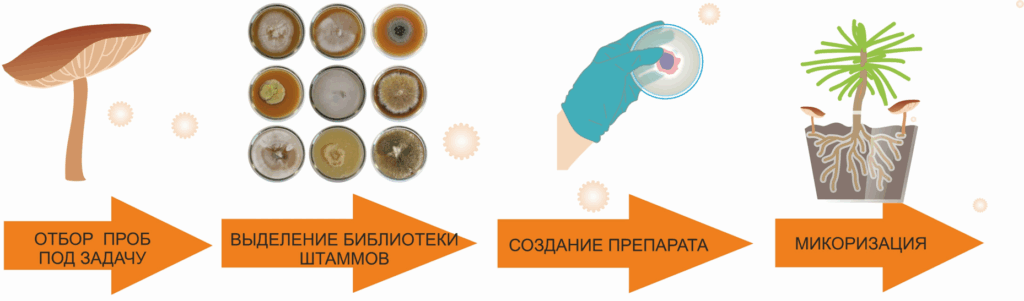

На базе лаборатории Микологии и микотехнологии с 2025 года ведется разработка микоризных препаратов на основе эктомикоризных грибов для улучшения роста насаждений.

Летом 2025 года было выделено в чистую культуру более 600 штаммов грибов разных групп; после отсева и анализа в коллекции осталось около 100 штаммов чистых культур эктомикоризных видов (из родов Laccaria, Suillus, Amanita и др.).
Все штаммы были подтверждены секвенированием. Характеристики штаммов внесены в базу данных коллекции и отображаются на порталах коллекции и Глобальной информационной системы о биоразнообразии.
- В сентябре 2025 года открыта выставка, посвященная микоризному симбиозу и результатам проекта: Подземный союз, как грибы спасают растения и климат
- Осенью 2025 года проект участвует в Акселераторе технологических стартапов: Микорост: препарат для лесоводства и лесовосстановления
Работа ведется в рамках реализации Соглашения № 2024-514-04 «Разработка микоризных препаратов для увеличения приживаемости древесных пород для биоремедиации и реализации климатических проектов»
